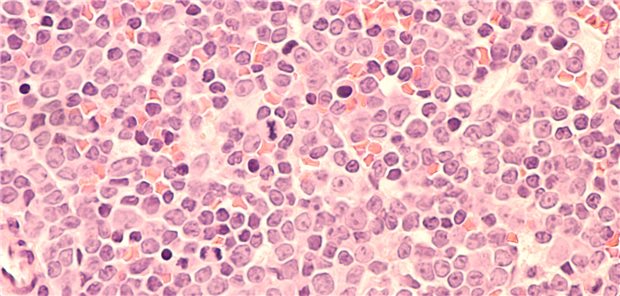
Das diffus großzellige B-Zell-Lymphom (DLBCL) schreitet rasch voran. Nach einem Rückfall zählt Rituximab + Gemcitabin-Oxaliplatin zu den Standardtherapien. In der waveLINE-003-Studie wurde diese jetzt mit Zilovertamab-Vedotin kombiniert.

04.06.2025
|
04.06.2025
|
Erste prospektive, randomisierte Studie
Adjuvante Immunchemotherapie könnte neue Option bei lokal begrenztem Kolonkarzinom werden
03.06.2025
|
Mikrobiom im Fokus
Wie Polyphenole und Bakterien Krebstherapien wirksamer machen könnten
03.06.2025
|
Chronische lymphatische Leukämie
Zeitlich begrenzte CLL-Therapie wohl auch bei genetischen Alterationen möglich
02.06.2025
|
Mit Antikörper-Wirkstoff-Konjugat
Neue Kombination beim diffus-großzelligen B-Zell-Lymphom geprüft
04.06.2024
|
Relaps-freies Überleben verlängert
Malignes Melanom: Neue Ära beim resezierbaren Tumor im Stadium III?
04.06.2024
|